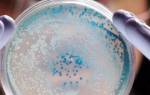
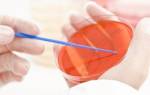

Остеохондроз позвоночника — распространенное заболевание, затрагивающее миллионы людей и ухудшающее качество жизни. В статье рассмотрим основные симптомы, причины, механизмы развития, а также методы лечения и профилактики. Понимание этих аспектов поможет читателям распознать заболевание, обратиться за медицинской помощью и выбрать оптимальные способы борьбы с недугом, что способствует улучшению здоровья и предотвращению осложнений.
Причины остеохондроза
Многие люди связывают остеохондроз с особенностями прямохождения. Однако на самом деле ни одно четвероногое животное не сталкивается с этой проблемой. Главная причина возникновения остеохондроза заключается в неравномерном распределении нагрузки на позвоночник, что приводит к ослаблению мышечного корсета. Поэтому тренировки, направленные на укрепление мышц спины, могут быть эффективными в борьбе с этим заболеванием.
Существует ряд факторов, которые могут увеличить риск развития остеохондроза:
- ослабление мышечного корсета из-за малоподвижного образа жизни;
- чрезмерные физические нагрузки;
- избыточный вес;
- различные травмы спины;
- неправильная осанка и длительное пребывание в неудобных позах, например, во время работы;
- нарушения обмена веществ;
- недостаток витаминов и микроэлементов в рационе.
Даже при соблюдении оптимального режима дня остеохондроз может развиваться из-за нехватки необходимых организму веществ. В настоящее время эта проблема становится все более актуальной, так как рацион современного человека часто избыточно насыщен быстрыми углеводами, польза которых вызывает сомнения.
Врачи подчеркивают, что остеохондроз позвоночника — это распространенное заболевание, проявляющееся разнообразными симптомами. К основным признакам относятся боли в спине, ограничение подвижности, а также онемение и покалывание в конечностях. Эти симптомы могут значительно ухудшать качество жизни, поэтому важно вовремя обратиться к специалисту.
Лечение остеохондроза обычно предполагает комплексный подход: медикаментозную терапию для снятия боли и воспаления, физиотерапию и лечебную физкультуру. Врачи акцентируют внимание на том, что изменение образа жизни — регулярные физические нагрузки, правильная осанка и сбалансированное питание — могут существенно замедлить прогрессирование заболевания. В некоторых случаях может потребоваться хирургическое вмешательство, однако это рассматривается как крайняя мера. В целом, ранняя диагностика и адекватное лечение способствуют улучшению состояния пациентов и предотвращению осложнений.
Эксперты в области ортопедии и неврологии подчеркивают, что остеохондроз позвоночника является распространенной проблемой, затрагивающей людей всех возрастов. Основные симптомы включают боли в спине, ограничение подвижности, а также возможные радиирующие боли в конечностях. Важно отметить, что ранняя диагностика и комплексный подход к лечению могут значительно улучшить качество жизни пациентов. Специалисты рекомендуют сочетание медикаментозной терапии, физиотерапии и лечебной физкультуры. В некоторых случаях может потребоваться мануальная терапия или массаж. Также эксперты акцентируют внимание на важности профилактики, включая регулярные физические нагрузки и правильную осанку, что может помочь избежать обострений и снизить риск развития осложнений.

Факторы риска
Больше всего страдают люди после 30 лет. Также особенно рискуют представители малоподвижных профессий – инженеры, программисты, бухгалтера и т. д.
Немаловажный фактор – лишний вес и плохие привычки. Остеохондроз поражает от 50 до 90% населения всей планеты. Первые признаки могут появляться еще в пубертатном периоде.
| Симптом | Возможная локализация | Рекомендации по лечению |
|---|---|---|
| Боль в спине (острая, ноющая, тупая) | Поясничный, грудной, шейный отдел позвоночника | Физиотерапия (УВЧ, электрофорез, магнитотерапия), массаж, лечебная физкультура (ЛФК), мануальная терапия (при необходимости и под контролем специалиста), нестероидные противовоспалительные препараты (НПВП) |
| Ограничение подвижности | Поясничный, грудной, шейный отдел позвоночника | ЛФК, растяжка, плавание |
| Мышечные спазмы | Поясничный, грудной, шейный отдел позвоночника | Миорелаксанты (по назначению врача), тепловые процедуры (в зависимости от стадии), массаж |
| Онемение и покалывание | Руки, ноги, туловище (в зависимости от пораженного отдела) | НПВП, витамины группы В, ЛФК |
| Головная боль, головокружение | Шейный отдел позвоночника | ЛФК для шеи, массаж воротниковой зоны, НПВП (при сильной боли), консультация невролога |
| Радикулит (боль, иррадиирующая по ноге или руке) | Поясничный или шейный отдел позвоночника | НПВП, миорелаксанты, ЛФК, в тяжелых случаях – блокады |
| Ограничение дыхания | Грудной отдел позвоночника | ЛФК для грудного отдела, дыхательная гимнастика |
Интересные факты
Вот несколько интересных фактов о симптомах и лечении остеохондроза позвоночника:
-
Разнообразие симптомов: Остеохондроз может проявляться не только болями в спине, но и такими симптомами, как головные боли, головокружение, онемение конечностей и даже проблемы с сердцем. Это связано с тем, что изменения в позвоночнике могут оказывать давление на нервы и сосуды, что приводит к различным неврологическим и сосудистым нарушениям.
-
Роль физической активности: Регулярные физические упражнения и поддержание активного образа жизни могут значительно снизить риск развития остеохондроза и облегчить его симптомы. Упражнения на растяжку и укрепление мышц спины помогают улучшить гибкость и поддерживают здоровье позвоночника.
-
Современные методы лечения: В дополнение к традиционным методам лечения, таким как медикаменты и физиотерапия, в последние годы все большее внимание уделяется альтернативным методам, таким как мануальная терапия, акупунктура и использование современных технологий, например, лазерной терапии. Эти методы могут помочь уменьшить боль и улучшить качество жизни пациентов с остеохондрозом.

Стадии остеохондроза позвоночника
-
Первая стадия остеохондроза. Высота межпозвоночного диска уменьшается из-за потери влаги в пульпозном ядре. На этом этапе заболевание затрагивает только межпозвоночные диски.
-
Вторая стадия остеохондроза. С уменьшением высоты диска точки крепления связок и мышц становятся ближе друг к другу. Это приводит к нестабильности в движении позвонков. На данной стадии также может происходить смещение или соскальзывание позвонков относительно друг друга.
-
Третий этап остеохондроза. На межпозвоночных дисках формируются протрузии и пролапсы. В межпозвонковых суставах развиваются артрозы и подвывихи.
-
Четвертая стадия остеохондроза. На этом этапе происходит дегенеративное восстановление позвоночника, проявляющееся в адаптивных изменениях. Организм приспосабливается и справляется с избыточной подвижностью позвонков. В результате образуются остеофиты или костные наросты. Постепенно заболевание приводит к тому, что позвоночник становится жестким и неподвижным.
Остеохондроз позвоночника — это широко распространенное заболевание, о котором говорят многие. Люди часто упоминают такие симптомы, как боли в спине, онемение конечностей и ограничение подвижности. Эти проявления могут существенно снизить качество жизни, и многие обращаются к врачам за помощью. Лечение может варьироваться от консервативных методов, таких как физиотерапия и массаж, до медикаментозной терапии и, в крайних случаях, хирургического вмешательства. Многие отмечают, что регулярные физические упражнения и правильная осанка помогают облегчить симптомы. Также популярны народные средства, такие как компрессы и травяные настои, хотя их эффективность часто вызывает споры. Важно помнить, что подход к лечению должен быть индивидуальным и согласованным с врачом.
Симптомы остеохондроза
При развитии остеохондроза зачастую проявляются следующие симптомы, которые связаны с неприятными ощущеними в одном или нескольких отделах позвоночника. Дискомфорт и боль могут быть незначительными, а порой становятся тупыми, сильными, тянущими и даже нестерпимыми – при прострелах.
Кроме этого, проявляются такие признаки заболевания:
- зябкость ног и рук, излишняя чувствительность в разных частях на теле.
- боль в плече, лопатке, затылке, шее.
- быстрая утомляемость при любых физических напряжениях, а также при умственной работе.
- боль, отдающая в ноги.
При шейном остеохондрозе происходит головокружение, снижение остроты зрения, появляется быстрая утомляемость глаз.
При поясничном остеохондрозе возможны проблемы со стороны сексуальной сферы, а именно дисфункции различного плана. Именно поэтому у многих пациентов мужского пола после лечения остеохондроза активизируется мужская сила. Для женщин крестцово-поясничный отдел и нормализация его работы означает нормальное протекание беременности и легкое зачатие.
Симптомы грудного остеохондроза следующие: боль, онемение и появление «мурашек» возле груди, живота и в ногах. Многие признаки остеохондроза грудного отдела неспецифичны, поэтому болезнь легко перепутать с какой-либо другой патологией. Впрочем, грудной остеохондроз случается редко.

Диагностика остеохондроза позвоночника
Остеохондроз диагностируется специалистом-неврологом. В процессе обследования позвоночника врач оценивает его состояние в различных положениях: стоя, сидя и лежа, а также в движении и в состоянии покоя. С помощью специальной схемы специалист может выявить деформации и степень поражения позвоночного столба.
Во время диагностического осмотра врач обращает внимание на осанку, индивидуальные особенности тела пациента, а также фиксирует линии остистых отростков, нижние углы лопаток, рельеф мышц и контуры талии и шеи. При пальпации позвоночника удается дополнить данные визуального осмотра, определить локализацию, степень и характер поражения.
В области позвоночника может наблюдаться перенапряжение мышц и повышенный тонус. Пациента часто просят выполнить наклоны, что позволяет оценить амплитуду движений в каждом отделе позвоночника. Что касается медицинских исследований, то наиболее информативными являются рентгенография, компьютерная томография и магнитно-резонансная томография. Современные методы диагностики помогут вам и вашему врачу точно определить степень поражения позвоночника, уточнить диагноз и выявить сопутствующие проблемы и патологии.
После завершения диагностики врач сможет рекомендовать наиболее эффективное лечение и дальнейшие меры профилактики.
Лечение остеохондроза
Можно проводить лечение остеохондроза в домашних условиях. Если же консервативное лечение не эффективно, применяется хирургическое или другими словами оперативное вмешательство. В зависимости от поражения и развития болезни понадобятся определенные объемы оперирования остеохондроза.
Продолжительность терапии зависит от возрастного изменения, степени заболевания, прилежности выполнения рекомендаций врача. Зачастую достаточно одного или пару месяцев для того, что подействовали консервативные методы лечения. Если речь идет об оперативном вмешательстве, восстановление займет примерно один год.
Некоторые пациенты в самом начале терапии ощущают увеличение болей. Это происходит, поскольку мышечная система так реагирует на новое влияние. Боль скоро исчезает благодаря использованию современных техник массажа, мануальной терапии, а также медицинских препаратов. От больного требуется воля и настойчивость, определенное терпение до полного выздоровления. Немаловажен положительный настрой.
Что в себя включает лечение остеохондроза? Это физиотерапия, массаж, физкультура, вытяжение позвоночника, медицинские препараты, а также рефлексотерапия.
- 1) Основным методом считают лечебную физкультуру (см. упражнения при остеохондрозе). В данном случае пациенту врач выписывает специальные упражнения, направленные на укрепление мышц, выработку нормального движения и создания гармоничной осанки. Суставная гимнастика и реабилитационное оборудование позволит увеличить кровообращение, улучшить обмен веществ в тканях, сформировать нормальный мышечный корсет, уменьшить нагрузки на позвоночник.
- 2) Физиотерапия, а именно магнитотерапия, лазерная терапия, токи низкой частотности, ультразвук помогают снять болезненность, воспалительные процессы, а также помочь пациенту реабилитироваться после перенесенной операции. Благодаря тому, что при лечении физиотерапевтическими методами снижается риск возникновения осложнений, увеличивается польза от медикаментозной терапии, улучшаются обменные процессы в организме и позвоночнике в частности, этот метод очень актуален.
- 3) Массаж помогает снять напряжение в мышцах, активизировать иммунитет, убрать боли. Для того чтобы он был эффективным, а не повредил позвоночнику, следует обращаться к специалисту.
- 4) Мануальная терапия – еще один метод борьбы с остеохондрозом. Помогает снять болевые ощущения и увеличить диапазон движений, подкорректировать осанку. Восстанавливается нормальная подвижность органов, улучшается движение лимфы и крови, обмен веществ, иммунитет, что крайне важно для лечения остеохондроза.
- 5) Тракция или специальное вытяжение позвоночника улучшает межпозвоночное пространство, снимает боль, восстанавливая гармоничную форму позвоночника и спины, в общем. Для данной процедуры необходимо специальное оборудование.
- 6) При остеохондрозе с болями, неуравновешенностью, лишними килограммами и проблемами со сном используют такой способ лечения как рефлексотерапия. Врач влияет на специальные акупунктурные точки, стимулирует природное выздоровление организма, приводя организм в гармоничное состояние.
Чтобы снять воспалительный процесс, убрать боль, а также усилить обмен веществ в зоне спины и позвоночника, используются медицинские препараты, в основном это таблетки и мази. Фастум гель, Финалгон, Долобене гель, Хондроксид имеет различное влияние на ткани и на организм в целом.
Для массажа рекомендуется использовать пчелиный яд и мумие. Компоненты, содержащиеся в этих мазях, помогают снять боль, улучшить кровообращение, оказывают регенерирующее и противовоспалительное воздействие. Анальгин и Кетанов применяют по рекомендации врача при болях.
Лечение остеохондроза народными средствами
В основном остеохондроз лечится в домашних условиях с использованием как химических, так и растительных препаратов. Народные средства, такие как спирт, скипидар и анальгин, помогают облегчить боль, согревают, улучшают кровообращение и уменьшают спазмы.
Вот один из рецептов, который отлично подойдет для снятия сильной боли. Рекомендуется использовать растирку для быстрого облегчения дискомфорта.
Уже после 4-5 процедур вы сможете ощутить значительное улучшение.
Ингредиенты для растирки:
- десять таблеток анальгина;
- небольшое количество йода;
- 300 мл медицинского спирта;
- 10 мл камфарного спирта.
Все компоненты тщательно перемешиваются до полного растворения. Эта смесь эффективно помогает при болях, если ею натирать пораженные участки. После нанесения возможно ощущение жжения. Не рекомендуется использовать раствор на поврежденной коже.
При необходимости применяйте этот раствор, и он обязательно поможет снять боль.
Какова же курсовая терапия при остеохондрозе? Если таблетки оказывают лишь незначительное воздействие, попробуйте это средство. Вы заметите улучшение своего состояния уже через несколько месяцев.
Для приготовления лечебной смеси вам понадобятся два состава:
- 50 мл камфарного спирта и водки, 50 г сухого порошка горчицы, 3 взбитых яичных белка. Все ингредиенты смешиваются и настаиваются в течение 12 часов.
- 150 мл водки, 50 г алоэ, 100 г меда. Этот состав также тщательно перемешивается и настаивается в течение того же времени.
Эти смеси используются для лечения различных отделов позвоночника.
Как применять? Необходимо наносить смесь в виде компресса на проблемный участок позвоночника. Компрессы следует использовать дважды в день. Можно взять обычную ткань, смочив ее раствором. Курс лечения следующий: 3 дня используйте первый состав, затем 3 дня – второй, после чего чередуйте их по три дня. Вы сможете добиться значительного облегчения, если будете следовать этому режиму без перерывов.
Гимнастика при остеохондрозе
Ее можно выполнять после того, как пройдет острая стадия болезни.
При
шейном типе остеохондроза
рекомендованы такие упражнения:
- голову нужно запрокинуть назад. Правым ухом коснитесь правого плеча, а после этого левым прикоснитесь к левому плечу. Повторить несколько раз.
- опустите подбородок к шее. Аккуратно поворачивайте голову влево, а затем вправо.
- немного покачивайте голову, сначала как будто вы машете «нет», а затем будто с чем-то соглашаетесь.
При
поясничном остеохондрозе
рекомендовано:
- поочередное поднятие правой ноги и левой руки, стоя на четвереньках. Затем наоборот.
- повороты торса лежа на спине в разные стороны.
- притягивание колен к груди.
- прогибание и выгибание спины, стоя на коленках.
Для разминки и эффективной гимнастики используйте также гимнастический большой мяч.
Осложнения остеохондроза
Игнорирование лечения остеохондроза может привести к ряду серьезных осложнений:
- люмбаго;
- радикулит;
- межпозвоночная грыжа;
- остеофитоз;
- вегетососудистая дистония (ВСД);
- инвалидность;
- мигрени;
- ишиас;
- спондилолиз.
Чтобы избежать этих и других негативных последствий, важно своевременно обратиться к врачу.
Профилактика остеохондроза позвоночника
Какие рекомендации можно дать людям, стремящимся провести профилактику остеохондроза?
- 1) Рациональное питание. Очень важно, чтобы в вашем рационе было достаточное количество витаминов, минералов. Пряности, специи, соусы, блюда на пару и в духовке, обязательно животный белок – все это должно быть на вашем столе. А вот количество соли, а также соленых продуктов, сахара, быстрых углеводов, винограда, алкоголя, кофе следует ограничить. Питаться лучше всего дробно, примерно пять-шесть раз в день. Не забывайте о пользе кисломолочных продуктов: доказано, что из-за нехватки кальция возникает остеохондроз. При нехватке того либо иного витамина или минерала врач назначит их прием дополнительно.
- 2) Массаж. Даже самостоятельно вы можете проводить ежедневную процедуру самомассажа. Для этого хорошо, но аккуратно массируйте спину, поясницу, ноги.
- 3) Физкультура. Подобрать упражнения для спины и всего тела сегодня легко. Главное выделить для этого время: достаточно 10 минут на рабочем месте или дома, чтобы ослабить давление на позвоночник. Если у вас уже был остеохондроз, тогда выполняйте специальную вытяжку позвоночника.
- 4) Плавание. Если есть такая возможность, плавайте в бассейне на спине. Это поможет разгрузить спину.
- 5) Больше движений. В обеденный перерыв или вечером гуляйте пешком. Такая, простая на первый взгляд, прогулка поможет активизировать обменные процессы.
Как понять, что у тебя остеохондроз позвоночника?
Слабая, но постоянная боль, которая усиливается при движении, может отдавать в плечи, голову, ноги и таз. Также наблюдаются непрекращающиеся мышечные спазмы, снижение работоспособности, проблемы со сном, изменения в осанке и походке, а также слабость в ногах (особенно при остеохондрозе поясничного отдела).
Какое самое хорошее лекарство от остеохондроза?
Преднизолон. Метилпреднизолон. Дексаметазон. Дипроспан. Кеналог. Флостерон.
Какие симптомы может давать остеохондроз?
Боль, которая может проявляться в области шеи, плеч, поясницы и даже в ребрах. Чувство жесткости в спине и поясничной области. Ощущение онемения в конечностях. Мышечные спазмы или чувство слабости в них. Озноб и дискомфорт в теле. Увеличенная утомляемость. И другие симптомы.
Где болит при остеохондрозе позвоночника?
Умеренная тупая боль в течение суток, усиливающаяся во время движений, распространение боли в область головы, плеча, таза и нижних конечностей, постоянное напряжение мышц, связанных с пораженным межпозвоночным суставом, снижение работоспособности, нарушение сна,
Роль питания в лечении остеохондроза
Правильное питание играет важную роль в лечении остеохондроза позвоночника, так как оно способствует улучшению общего состояния организма, укреплению костной и хрящевой ткани, а также снижению воспалительных процессов. Важность рациона заключается в том, что определенные продукты могут помочь восстановить здоровье позвоночника, улучшить обмен веществ и обеспечить организм необходимыми питательными веществами.
Во-первых, необходимо обратить внимание на достаточное потребление белка. Белки являются строительным материалом для клеток и тканей, включая хрящи. Рекомендуется включать в рацион нежирные сорта мяса, рыбы, яйца, бобовые и молочные продукты. Особенно полезны рыбы, богатые омега-3 жирными кислотами, такие как лосось и скумбрия, которые обладают противовоспалительными свойствами.
Во-вторых, важно обеспечить организм достаточным количеством витаминов и минералов. Витамины группы B, витамин D, кальций и магний играют ключевую роль в поддержании здоровья костей и хрящей. Витамин D способствует усвоению кальция, что особенно важно для профилактики остеопороза. Продукты, богатые этими веществами, включают молочные продукты, зелень, орехи, семена и цитрусовые.
Также стоит обратить внимание на антиоксиданты, которые помогают бороться с воспалением и окислительным стрессом. Фрукты и овощи, такие как ягоды, шпинат, брокколи и морковь, содержат большое количество антиоксидантов и должны составлять основу рациона. Они не только способствуют улучшению общего состояния здоровья, но и помогают в восстановлении тканей.
Кроме того, необходимо избегать продуктов, которые могут усугубить состояние. Это касается избыточного потребления сахара, соли, насыщенных жиров и переработанных продуктов. Они могут способствовать воспалению и ухудшению обмена веществ, что негативно сказывается на состоянии позвоночника.
Не менее важным аспектом является поддержание водного баланса. Достаточное количество жидкости помогает поддерживать эластичность межпозвоночных дисков и предотвращает их дегидратацию. Рекомендуется пить не менее 1,5-2 литров воды в день, а также включать в рацион супы и свежие фрукты, богатые влагой.
В заключение, правильное питание является важным компонентом комплексного подхода к лечению остеохондроза. Сбалансированный рацион, богатый необходимыми питательными веществами, поможет не только улучшить состояние позвоночника, но и повысить общее качество жизни. Однако перед внесением изменений в свой рацион рекомендуется проконсультироваться с врачом или диетологом, чтобы учесть индивидуальные особенности и потребности организма.
Вопрос-ответ
Что лучше всего помогает от остеохондроза?
В лечении шейного остеохондроза наиболее эффективными считаются НПВП и миорелаксанты, облегчая острые симптомы, в то время как витаминные и минеральные уколы для лечения шейного остеохондроза, препараты для улучшения метаболизма в хрящах и хондропротекторы выполняют вспомогательную функцию.
Куда может отдавать остеохондроз позвоночника?
Остеохондроз может поражать любой отдел позвоночного столба, т. е. шейный (ШОП), грудной (ГОП), поясничный (ПОП) отделы. Речь идет о процессе, который обычно возникает постепенно, сопровождается болями в спине, изначально появляющимися при физических нагрузках.
Советы
СОВЕТ №1
Регулярно выполняйте физические упражнения, направленные на укрепление мышечного корсета спины. Это поможет поддерживать позвоночник в правильном положении и снизит нагрузку на межпозвоночные диски.
СОВЕТ №2
Следите за осанкой, особенно если вы много времени проводите за компьютером или в сидячем положении. Используйте эргономичную мебель и делайте перерывы для разминки каждые 30-60 минут.
СОВЕТ №3
Обратите внимание на свой рацион. Употребление продуктов, богатых кальцием и витаминами D и K, поможет укрепить кости и суставы, что важно для профилактики остеохондроза.
СОВЕТ №4
Не игнорируйте симптомы, такие как боль в спине или ограничение подвижности. При первых признаках остеохондроза обратитесь к врачу для диагностики и назначения адекватного лечения.